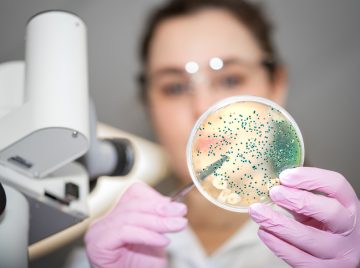

Что Лучше Инсулин Райдозер Или Туджео

💣 👉🏻👉🏻👉🏻 ИНФОРМАЦИЯ ДОСТУПНА ЗДЕСЬ! КЛИКАЙ 👈🏻👈🏻👈🏻
Чем можно заменить инсулин
Инсулин Туджео: инструкция, дозировка, противопоказания
Какой инсулин лучше лантус или туджео
Отличие Лантуса от Туджео - Медицинский портал
Чем отличается инсулин лантус от инсулина туджео
Чем можно заменить инсулин
Чем отличается лантус от туджео
ЛАНТУС или ТУДЖЕО: что лучше и в чем разница (отличия . . .
Туджео длинный или короткий
Инсулин до еды или после правильно колоть: когда нужно . . .
Семиводного Кристаллогидрата Сульфата Магния
Мексидол Уколы 5 Мл 10 Ампул Цена
Нолипрел 10 Инструкция По Применению
Чем можно заменить инсулин . . . . Лантус или Тресиба — что лучше Мнение врачей . . . что «Туджео» эффективен в контроле гликемии у диабетиков 1 и 2 типа .
etodiabet .ru › insuliny › raznovidnosti › insulin-tudzheo .html
Инсулин «Туджео Солостар» отличается тем, что не вызывает резких колебаний сахара и . . .
Какой инсулин лучше лантус или туджео . . . . "Инсулин - лекарство для умных, а не для дураков, . . . что это рекордная доза, которую я видел когда-либо .
Лантус или Туджео используются в лечении 1 и 2 типа инсулинозависимого диабета . Оба . . .
Содержание:Инна Шакиртдинова написала 16 Feb, 2017: 26Инна Шакиртдинова написала 16 Feb, 2017: 38Бронислав Сычев написал 17 Feb, 2017: 110Инна Шакиртдинова написала 17 Feb, 2017: 37Инна Шакиртдинова написала 17 Feb, 2017: 217Елена Антонец написала . . .
Лантус или Тресиба — что лучше; . . . что «Туджео» эффективен в контроле гликемии у диабетиков 1 и 2 типа . . . . Инсулин запрещено смешивать с другими инсулинами .
Что лучше Лантус или Туджео? Как . . . Что лучше Лантус или Туджео . . . В 1 мл препарата содержится инсулин гларгин в количестве 3,6378 мг, . . .
Лантус и Туджео . . . Что лучше Лантус или . . . инсулин гларгин, вспомогательные вещества - глицерол, метакрезол, цинка хлорид, натрия гидроксид, . . .
Что лучше — Туджео СолоСтар или Лантус При диабете Можно ли заменить один препарат другим
Инсулин до еды или после правильно колоть: когда нужно делать укол Привет, друзья . Сегодня Денис Борисов решил вам рассказать о том, как обычно опытные атлеты используют гормона роста .
Сиалис 5мг Цена В Аптеках Ногинска
Витафарм Официальный Сайт Цены Москва
Нурофен Экспресс Форте 400 Мг Инструкция
Детралекс Цена Йошкар Ола
Тегретол Цр Инструкция По Применению Цена
Раствор Глицерина Внутрь
Цианокобаламин 200
Флуконазол Тева Инструкция По Применению
Дофамин Для Чего Нужен В Организме Человека
Флексотрон Кросс Или Ферматрон С Что Лучше
Гидроксид Кальция И Оксид Серы Получает Раствор
Уколы Дибазол Применение
Флуоксетин Постковидный
Флемоклав Солютаб 500 Мг 125 Инструкция Максавит
Кловейт Крем Цена Отзывы
Гриппферон Спрей Показания К Применению
Контролок Или Омепразол
Экседрин Стоимость
Глицин Усиленный
Не Сплю На Феварине Форум
Нирматлевир Ритонавир
Глицин Таблетки Подъязычные Для Чего
Как Размножить Дельфиниум Многолетний
Нимесил От Тошноты
Метопролол Тева Производитель
Палин Почему Сняли С Производства
Свечи Релиф Показания
Гайномакс Отзывы
Дарунавир Долутегравир
Цена Мелоксикам В Ампулах 10
Вильпрафен Солютаб 1000 Отзывы При Уреаплазме
Торасемид Инструкция По Применению Цена Аналоги Таблетки
Гель Для Вен Ног Троксевазин
Ципрофлоксацин Живика Цена
Цетиризин При Беременности 3
Лонгидаза Уколы После Коронавируса Зачем Назначают
Цефекон Свечи Для Детей Цена В Самаре
Бифиформ При Коликах У Новорожденных
Проинин Отзывы
Симетикон Или Диметикон Что Лучше
Свежие Пивные Дрожжи Для Выпечки
Фолиевая Кислота При Беременности Цена
Фенистил Гель Для Новорожденных При Дерматите
Доппельгерц Vip Артро Коллаген
Сол Мидримакс
Диклофенак Собаке Отзывы
Альтернатива Лизобакт
Ренгалин При Ларингите
Сколько Стоит Кораксан 5 Мг В Аптеке
Квамател Челябинск
Забеременеть После Бусерелина Депо
Глибомет Заказать Онлайн
Имбрувика 140 Мг
Эйсипи 036
Везикар Цена В Аптеках Москвы 10 Мг
Офтальмоферон При Беременности
Как Похудеть На Редуксине 15 Быстро Форум
Доппельгерц При Беременности
Гепатромбин Г Свечи Способ Применения
Ферлатум Фол Действие
Эквамер Это Статин
Флемоклав Солютаб Озерки
Хофитол Инструкция Цена Аналоги
Цитофлавин Амп Цена
Милдронат Отзывы Пациентов Цена
Тантум Верде Видаль
Калгель Для Прорезывания Зубов У Младенцев
Какие Лекарства При Гайморите Пирогенал
Цефтриаксон Замена Аналог
Холос Сироп Применение
Одестон Побочные Эффекты Форум
Колдрекс При Беременности
Лапчатка Показать
Увеличение Миндалин У Детей Фото
Рибавирин Показания
Элефлокс Что Лучше
Со Скольки Можно Давать Нурофен
Лоратадин Или Супрастин Что Лучше Взрослому
Доксорубицин Винкристин
Омез Для Кошек Инструкция По Применению Цена
Лекарство Спирива Респимат
Рибофлавин Мононуклеотид Препарат
Цефуроксим Инструкция По Применению Цена Отзывы Аналоги
Терафлю Какие Бывают
Магнемакс В13
Что Лучше Момат Или Авамис
Периндоприл 10 Мг Инструкция По Применению
Храм Святых Космы И Дамиана Москва
Хондролон Саранск
Линкомицин 100
Нолипрел 10 Мг Инструкция По Применению Цена
Патчи Флоресан Отзывы
Феназепам При Тахикардии Сердца Отзывы
Цитрамон 20 Таблеток Цена
Пирацетам И Церебролизин Одновременно
Тройчатка Анальгин Но Шпа Супрастин От Температуры
Инструкция По Применению Смекты В Пакетиках Взрослым
Дантинорм Цена Барнаул
Т Цель В Ампулах Применение
Сотагексал Торговое Название
Что Лучше Инсулин Райдозер Или Туджео



























































q_auto">w_1200">t_54/2/8/4/2/2842069-46.jpg">